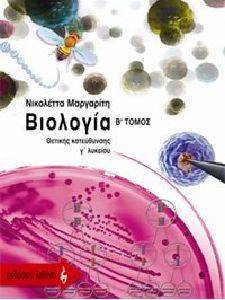
�������� � ������� ������� ����������� � �����

ΒΙΟΛΟΓΙΑ Γ ΛΥΚΕΙΟΥ ΘΕΤΙΚΗΣ ΚΑΤΕΥΘΥΝΣΗΣ Β ΤΟΜΟΣ 108068488
Εξαντλημένο
Εξαντλημένο
ΕΞΑΝΤΛΗΜΕΝΟ
ΒΙΟΛΟΓΙΑ Γ ΛΥΚΕΙΟΥ ΘΕΤΙΚΗΣ ΚΑΤΕΥΘΥΝΣΗΣ Β ΤΟΜΟΣ
108068488
ΓΕΝΙΚΗ ΠΕΡΙΓΡΑΦΗ
ΑΝΑΛΥΤΙΚΑ ΧΑΡΑΚΤΗΡΙΣΤΙΚΑ
Το παρόν βιβλίο αποτελεί έναν πλήρη οδηγό για την κατανόηση και τη διδασκαλία της Βιολογίας Γ Λυκείου Θετικής κατεύθυνσης.
Απευθύνεται:
Περιλαμβάνει:
ΠΡΟΒΟΛΗ ΟΛΗΣ ΤΗΣ ΠΕΡΙΓΡΑΦΗΣ

| Εκδότης : | Α. Α. ΛΙΒΑΝΗΣ |
| Σελίδες : | 480 |
| ISBN : | 978-960-14-1304-4 |
| Σειρά : | ΘΕΤΙΚΗΣ ΚΑΤΕΥΘΥΝΣΗΣ |
| Μήνας έκδοσης : | Σεπτέμβριος |
| Έτος έκδοσης : | 2008 |
ΠΡΟΒΟΛΗ ΟΛΩΝ ΤΩΝ ΣΤΟΙΧΕΙΩΝ

Είδατε πρόσφατα
-

ΒΙΟΛΟΓΙΑ Γ ΛΥΚΕΙΟΥ ΘΕΤΙΚΗΣ ΚΑΤΕΥΘΥΝΣΗΣ Β ΤΟΜΟ...
Περισσότερα -

ΚΑΠΟΥ ΑΛΛΟΥ
Περισσότερα -

THE PARADISE PROBLEM
Περισσότερα -

ΑΤΛΑΣ ΕΞΙ
Περισσότερα -

Ο ΚΡΥΦΟΣ ΑΣΟΣ
Περισσότερα -

ΟΙ ΟΡΓΑΝΩΤΙΚΕΣ ΚΑΙ ΔΙΟΙΚΗΤΙΚΕΣ ΑΡΜΟΔΙΟΤΗΤΕΣ Τ...
Περισσότερα -

ΧΡΙΣΤΟΥΓΕΝΝΙΑΤΙΚΗ ΧΑΡΑ ΜΕ ΠΑΙΧΝΙΔΙΑ ΠΟΛΛΑ!
Περισσότερα -

ΑΡΙΣΤΟΤΕΛΗ ΗΘΙΚΑ ΝΙΚΟΜΑΧΕΙΑ ΠΟΛΙΤΙΚΑ Γ ΛΥΚΕΙΟ...
Περισσότερα -

ΤΟ ΦΑΡΔΥ ΠΑΡΑΘΥΡΟ ΒΙΒΛΙΟ 3
Περισσότερα -

ΑΠΟΣΤΑΓΜΑΤΑ
Περισσότερα
|
Το καλάθι σας είναι άδειο |







